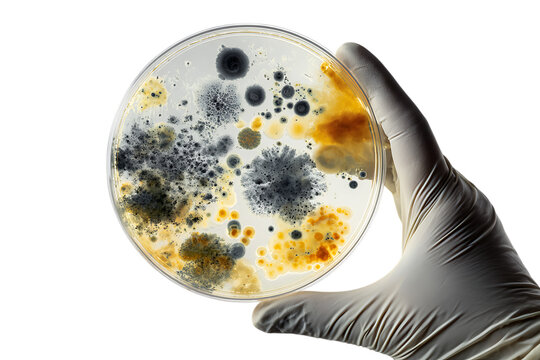
Filamentous fungi fermentation

Propagation for Lunar Ecosystems
Declaration of propogation of cultures for conversion of lunar regolith into biologically active substrate.
Research writing from the AstroBiota Observatory: biological programming, symbiosis, witness, trace, consequence, and state memory in living systems.
A growing archive of independent research papers, governance frameworks, and biological reference artifacts exploring witness, trace, and consequence in living and machine systems.
Declaration of propogation of cultures for conversion of lunar regolith into biologically active substrate.

A proposal for artifact-first scientific documentation: trace first, interpretation second.

Carbon computation under light gating: irreversible trace and embodied metabolic cost, coupled to silicon decision systems as a new silicon–carbon symbiotic machine class.

A conservation-first economic model built around preserving biological process rather than extracting biological objects — enabling continuous, non-destructive fermentation and real abundance.
A pilot invitation for mycelium and filamentous fungi teams: can history-dependent state conditioning reduce variance without changing DNA?

Proto-Lichen — a reproducible symbiotic morphology where tomentose fungal mycelium carries algal partners as a dry biofilm.